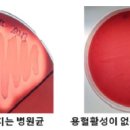
효능평가센터 이미지

효능평가센터 총82명이 열람하였으며, 0개의 리뷰가 있습니다.
- 번호
- 42,753
- 구분
- 공중화장실
- 근거
- 법제3조제17호-영제3조제2항제3호
- 화장실명
- 효능평가센터
- 소재지도로명주소
- 경기도 용인시 처인구 백령로20번길 27 (유방동)
- 소재지지번주소
- 경기도 용인시 처인구 유방동 653-1
- 남성용-대변기수
- 11
- 남성용-소변기수
- 6
- 남성용-장애인용대변기수
- 0
- 남성용-장애인용소변기수
- 0
- 남성용-어린이용대변기수
- 0
- 남성용-어린이용소변기수
- 0
- 여성용-대변기수
- 10
- 여성용-장애인용대변기수
- 0
- 여성용-어린이용대변기수
- 0
- 관리기관명
- 효능평가센터
- 전화번호
- 031-5186-6753
- 개방시간
- 미개방요일
- 개방시간상세
- 미개방
- WGS84위도
- 37
- WGS84경도
- 127
- 화장실소유구분
- 민간소유-법인
- 오물처리방식
- 수세식
- 안전관리시설설치대상여부
- 아니오
- 비상벨설치여부
- 아니오
- 비상벨설치장소
- 없음
- 화장실입구CCTV설치유무
- 아니오
- 기저귀교환대유무
- 아니오
- 기저귀교환대장소
- 없음
- 데이터기준일자
- 2024-12-31
블로그 리뷰
-
소비자평가 대상을 받았을 정도로 신뢰도가 높은 제품인데요. 운동량이 많은 국가대표 선수들이 직접 선택해서 관리하는 제품으로 알려지면서 저처럼 일상적인 관절 관리가 필요한 중년층 사이에서도 입소문이 자자하고 유명합니다. 픽셈 효능 좋은 이유는 성분을 알아보면 이해하실 수 있는데요. 순도 99.9%의 미국산...
(패션·미용)써볼게(2026-03-22 20:58:37)

-
사용 후기와 연구 사례가 존재합니다. 두 번째는 젖산칼슘입니다. 일반 탄산칼슘 계열의 원료와 비교했을 때 체내 흡수율이 높다는 것이 가장 큰 장점입니다...합성 칼슘에 비해 인체와의 친화성이 높다는 점에서 소비자들에게 긍정적으로 평가받고 있습니다. 이 세 가지 성분의 조합은 관절과 뼈 건강을 동시에 관리...
윗키T스토리(2026-04-10 13:16:12)

-
사용 후기! 안녕하세요 미즈옹입니다 제 블로그 보신 분들 아시겠지만 제가 탈모에 진심이잖아요 탈모에 좋다는 제품은 다 써보고, 홈케어 꾸준히 하는 사람!! 20대 때 풍성하던 앞머리가 지금은 밀도가 휑 낮아져서 조금만 밝은 데서 보면 앞머리가 텅 비어있거든요 ㅠㅠ 옆으로 넘기면 이 빈틈 뭔가요! 그래서...
미즈옹의 뷰티룸♡(2026-03-30 12:19:00)

-
꾸준히 사용하게 되었던 것 같아요. * 모발 빠짐 수 개선 효능 평가 | ㈜휴먼피부임상시험센터 / 성인 여성 23명 / 25.08.25 ~ 25.09.08 / 개인차 있음 * 두피...있음 그렇게 꾸준히 써보고 남겨보는 다노날 창포 두피세럼 한달 사용후기입니다. 저도 이번에 알게된 적나라한 저의 정수리! 가르마를 중심으로 한눈...
즐거운 생활, 미스정(2026-03-31 18:53:00)

-
원료 사용 이라는 점이 특징입니다. 또 인체 피부 투과 효능 평가도 진행된 제품이라고 합니다. 경희대학교 기술지주 자회사 피부생명공학센터에서 인체 피부 투과 효능 평가가 진행되었다고 합니다. 또 저자극 테스트까지 완료된 제품이라고 하니 피부에 사용하는 제품으로서 안심하고 사용할 수 있는 부분...
루프트러스 아치루프트러스 피라미드트러스 영상렌탈(2026-03-21 08:00:00)

-
객관적인 수치뿐만 아니라 실제 저의 2주 사용후기에서도 모발에 힘이 생기는 느낌을 충분히 받을 수 있었는데요~ *모발 빠짐 수 개선 효능 평가 : ㈜휴먼피부임상시험센터 / 성인 여성 23명 / 25.08.25~25.09.08 / 개인차 있음 *두피 탄력 개선 효능 평가 : ㈜휴먼피부임상시험센터 / 성인 여성 23명 / 25.08.25...
영업왕 제제의 블로그(2026-03-23 12:00:00)

-
주요 효능 추천 대상 1. 메리골드차 눈 건강의 제왕. 루테인이 풍부하여 황반변성 예방과 시력 보호에 탁월합니다. 스마트폰을 오래 보는 '가을'과 어르신들 2. 국화차 머리를 맑게. 해열 작용이 있고 두통과 어지러움을 가라앉힙니다. 스트레스가 심하고 혈압이 높은 분 3. 장미차 여성 호르몬 조절. 비타민 C가 레몬의...
대한인식생명교육 사회적협동조합(2026-02-25 21:32:00)

-
특허성분이 모근 깊숙이 영양을 전달합니다. 다노날 창포 바이 엑소좀 스칼프 세럼은 복잡한 과정 ... danonal.co.kr * 두피 온도 개선 효능 평가 | ㈜휴먼피부임상시험센터 / 성인 여성 23명 / 25.08.25 ~ 25.09.08 / 개인차 있음 * 모발 빠짐 수 개선 효능 평가 | ㈜휴먼피부임상시험센터 / 성인 여성 23...
길에서 만난 로라(2026-03-30 10:20:00)

-
세정 가능 ➡️ 응가 후 냄새 케어 및 항균(칸디다균) 제거 임상 테스트 완료 ✔️ 소취성 시험, KOTITI, 24.09.09~24.09.13 ✔️ 항균 인체 효능평가, ㈜글로벌의학연구센터, 24.09.19~24.10.18 언박싱 후기 바스앤샴푸베이비워시&엉덩이클렌저 좌측은 베이비워시, 우측은 엉덩이 클렌저입니다 eslo 이슬로 베이비라인 제품들...
아윤아준과 콩냥이(2025-06-09 20:36:00)

-
능력을 입증받았답니다. *피엔케이피부임상연구센타(주), 2025.08.26~2025.09.26, 항산화 효능 평가 완료 또한 2주 사용만으로 손상된 피부 장벽을 78% 개선...100%* 상승이라는 놀라운 수치를 기록했어요. *피엔케이피부임상연구센타(주), 2025.08.26~2025.10.21, 만 20~60세 성인 여성, 2주 사용 결과 4주간 사용...
핑키돼냥이의 슬로우에이징 뷰티(2026-03-25 11:40:00)

일별 방문 통계
월별 방문 통계
날씨
리뷰 (0)
등록된 리뷰가 없습니다.
첨부파일